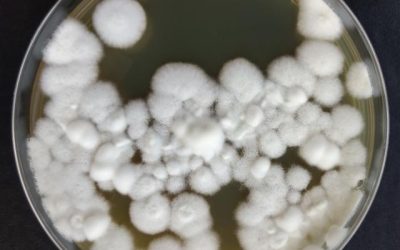
Pesquisa revela estratégia para controle de pragas agrícolas com fungo modificado

A produção de castanha-da-amazônia — também conhecida como castanha-do-brasil ou castanha-do-pará — sofreu forte retração na safra...
Tecnologia
Embrapa lança cultivares de soja com alta produtividade e resistência a doenças
Tecnologia de ponta, sanidade foliar e versatilidade no campo. Com esses atributos, a Embrapa e a Fundação Meridional acabam de apresentar...
Embrapa descobre 60 espécies de insetos no Brasil
Uma pesquisa da Embrapa, em colaboração com cientistas internacionais, identificou 60 novas espécies de psilídeos, insetos conhecidos como...
Pesquisa deve impulsionar a produção do Ovino Pantaneiro
A crescente demanda por carne ovina no Brasil abre espaço para a criação do Ovino Pantaneiro no Pantanal. Estudos da Embrapa...
Pesquisa revela estratégia para controle de pragas agrícolas com fungo modificado
Cientistas brasileiros e americanos conduziram uma pesquisa que pode revolucionar o controle de pragas nas lavouras. O estudo, que...
Avanço do Greening muda mapa da Citricultura no Brasil
O Huanglongbing (HLB), ou greening, considerada a pior doença dos cultivos de citros, está provocando a migração da produção no Brasil. O...
Preço do carbono na agricultura: estudo da Embrapa traz valor inédito
O preço das emissões de carbono na agropecuária brasileira foi estimado em US$ 11,54 por tonelada de gás carbônico equivalente (tCO2e). O...
Soluções sustentáveis para a serra gaúcha na Expodireto Cotrijal
Durante a Expodireto Cotrija, foi apresentado um modelo inovador para o uso sustentável das áreas de encosta da Serra Gaúcha. Desenvolvido...
Fungo na Antártica pode resultar em biopesticidas naturais
Uma importante descoberta de bioinsumos foi realizada por uma equipe de cientistas brasileiros e norte-americanos, que identificaram...
Pesquisa transforma resíduo do etanol de milho em combustível sustentável
Uma pesquisa do Centro Nacional de Pesquisa em Energia e Materiais (CNPEM), em Campinas (SP), revelou um novo caminho para a produção de...